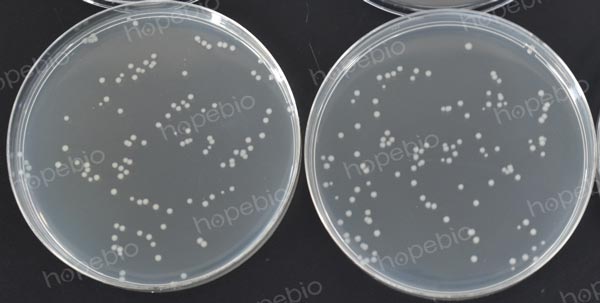
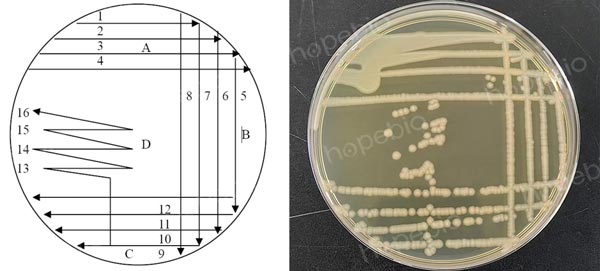

海博微信公众号
海博微信公众号
 海博天猫旗舰店
海博天猫旗舰店


 海博微信公众号
海博微信公众号
 海博天猫旗舰店
海博天猫旗舰店




一、非选择性分离/计数固体培养基的介绍
非选择性分离/计数固体培养基常用于细菌的计数、活化、分离纯培养等用途,含琼脂一般为1.2%-1.5%,可使用倾注法计数或制成平板涂布法计数使用,也可制成斜面用于菌种的传代保存,常见的有平板计数琼脂(PCA)、营养琼脂(NA)、胰蛋白胨大豆琼脂(TSA)等,培养基的组成为基础营养成分,无抑制性,一般不具有针对性,适用于大多数细菌的培养。
二、培养基的出厂检验-生长率测定
1.菌液制备
将质控菌株接种至非选择性肉汤或平板中进行活化培养(通常可使用TSB或TSA),使用生理盐水或磷酸盐缓冲液进行十倍系列稀释至适宜梯度。
2.培养基准备
将待测培养基及参比培养基按标签制备进行灭菌,制成平板备用(若采用倾注法接种,可将灭菌后的培养基置47-50℃水浴保温备用)。细菌通常用TSA做参比培养基,真菌通常使用SDA,有特殊营养要求的菌可选用适宜的无抑制性培养基做为参比培养基。
3.接种及培养
吸取0.1mL制备好的菌悬液,分别涂布至待测培养基和参比培养基,每平板接种水平为20-200CFU,至少接种2块平板,将接种好的培养基置于标准规定的条件下进行培养。
4.结果计算及判定
生长率PR=NS(待测平板菌落总数)/NO(参比培养基平板菌落总数,应≥100CFU),目标菌在待测培养基上应有典型的生长,生长率应不小于0.7。
三、培养基的验收方法
将质控菌株接种至非选择性肉汤培养基中过夜培养制成工作菌悬液,使用1μL接种环挑取1环菌液,按照标准的方法连续划16线,置于标准规定的温度培养,如果仅一半的线有稠密菌落生长,则G为0.5。如果划线上没有菌落生长、生长量少于划线的一半或菌落生长微弱,则G为0,计算G值总和,应达到G≥6。
注:本文属海博生物原创,未经允许不得转载。
上一篇:常见细菌的分类及介绍
下一篇:生孢梭菌的活化、保存及使用



